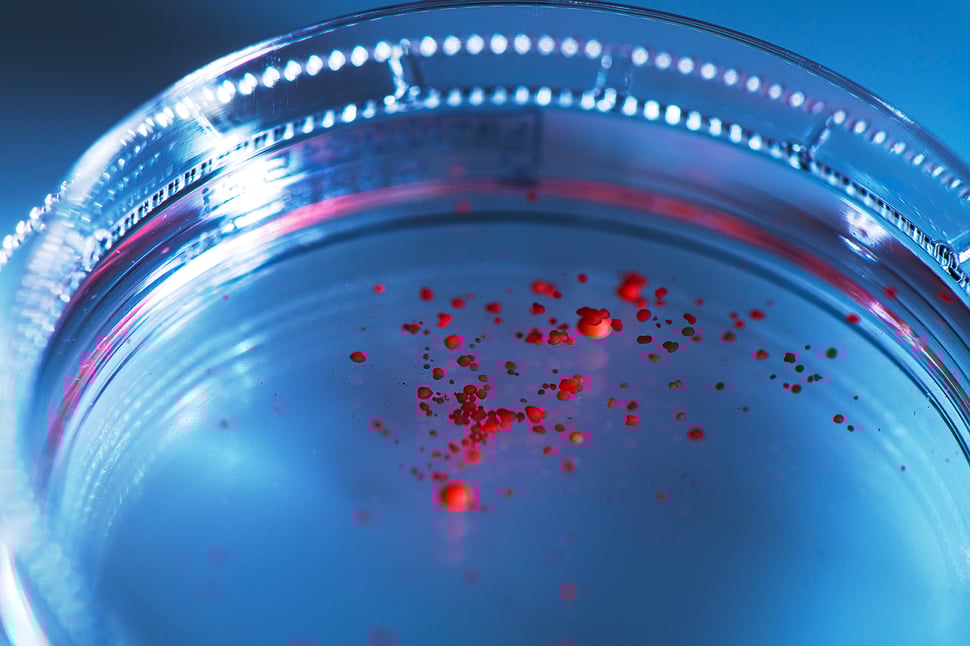
Fettzellen im Nährboden in Petrischale, Biotech, Industriefotografie, Fotograf Jürgen Müller

Seit über 20 Jahren steht Studio Jürgen Müller für hochwertige Fotografie im B2B-Bereich - Ich realisiere Businessporträts, Industriefotografie, Produkt- und Architekturfotografie – speziell für Unternehmen, Agenturen und Institutionen.
Ob Portraits für die Geschäftsleitung, Industriefotos Ihrer Produktionsanlagen, Produktaufnahmen für exklusive Marken oder Architekturfotografie internationaler Premiumimmobilien – ich visualisiere Arbeitssituationen, Produktionsprozesse und porträtiere Führungspersönlichkeiten aus Wirtschaft und Politik.
Meine Bildwelten entstehen für Firmenbroschüren, Geschäftsberichte, Webseiten und Corporate Communications.
Basierend in Bargteheide, ideal gelegen zwischen Hamburg und Lübeck, bin ich für Kunden aus der gesamten Metropolregion Hamburg und international im Einsatz.
Grundlage meines fotografischen Anspruchs sind maßgeschneiderte Bildkonzepte und professionelle Umsetzung auf einer soliden handwerklichen Basis. Ich realisiere Fotokampagnen, Anzeigenmotive und Imagebroschüren für Dienstleister, Markenartikler sowie Unternehmen der Industrie- und Finanzwirtschaft. Für Geschäftsberichte und Unternehmenskommunikation entwickle ich komplexe fotografische Illustrationen. Arbeitssituationen werden glaubwürdig inszeniert, Führungspersönlichkeiten aus Wirtschaft und Politik hochwertig porträtiert – für starke, authentische Unternehmensdarstellungen.
Zur kultivierten Positionierung Ihrer Produkte entwickle ich Ihnen eine individuelle Bildsprache und beschäftige mich intensiv mit dem Thema Markenkunst – Productart.
